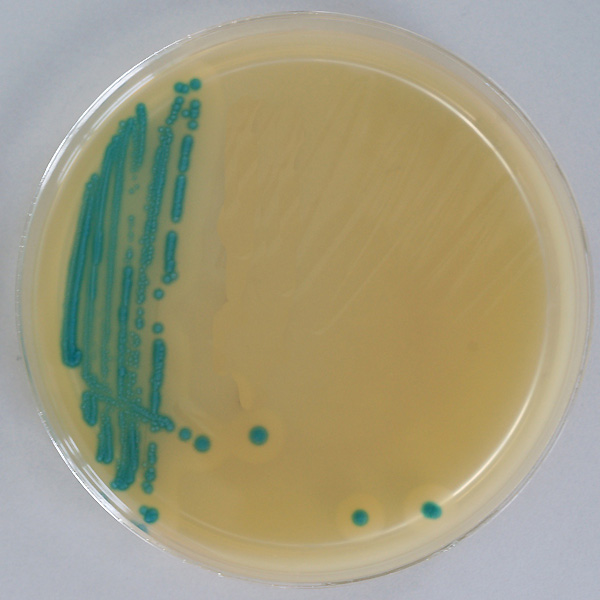

Listerien Abtöten Durch Erhitzen
Listerien abtöten durch erhitzen. Durch Erhitzen also beim Kochen Braten oder Pasteurisieren werden Listerien abgetötet. Verzehrt werden ohne weitere listerienabtötende Behandlung z. Achten Sie immer darauf dass das ganze Gericht gut durcherhitzt wird was zB.
Mit einfachen Lebensmittelhygiene-Maßnahmen können Sie zuverlässig Salmonellen abtöten. Die 65 über längere Zeit und das ausgiebige Spülen mit Wasser dazu noch das Spülmittel - das sind keine guten Bedingungen für Toxoplasmen oder Listerien. Listerien werden durch Pasteurisieren und durch Erhitzen abgetötet.
Wie kann man Listeriose feststellen. Aus diesem Grund ist es wichtig die Lebensmittel vor dem Verzehr ausreichend zu erhitzen 70C für mindestens 2 Minuten. Bei der ersten Erhitzung werden die vermehrungsfähigen Bakterien abgetötet und die Spo-ren können auskeimen und sich zu vermehrungsfähigen Bakterien entwickeln.
Beide Bakterienarten sind hitzeempfindlich und werden in einer gut funktionierenden Spülmaschine vernichtet. Listerien werden durch Pasteurisieren und durch Erhitzen abgetötet. Pasteurisierung werden Listerien abgetötet.
Generell lassen sich Listerien abtöten wenn sie bei über 65 Grad erhitzt werden. Es ist ein Irrglaube dass man Salmonellen durch gründliches Waschen abtöten kann. Die Mehrzahl der Listeriose-Fälle war mit dem Verzehr von Lebensmitteln assoziiert die nicht den gegenwärtig angewandten Richt- bzw.
Die Bakterien sitzen vor. Erhitzen Sie Ihre Lebensmittel bis zum Siedepunkt. Dadurch werden 99 aller Bakterien abgetötet.
Bei herkömmlichen pasteurisierten Milchprodukten wird die Milch stark erhitzt auf mind. Listerien sind Bakterien die in unserer Umwelt weit verbreitet sind.
Werden Listerien durch Pasteurisieren abgetötet.
Zwischen den beiden Erhitzungsvorgängen sollte das Einweckgut am besten bei Raumtemperatur gelagert werden. Bei der Wärmebehandlung von Milch u. Listerien werden durch Pasteurisieren und durch Erhitzen abgetötet. Lebensmittel können jedoch auch nach der Herstellung mit Listerien konta. Lebensmittel können jedoch auch nach der Herstellung mit Listerien kontaminiert werden beispielsweise nach dem Erhitzen noch vor dem Verpacken. Listerien werden durch Pasteurisieren und durch Erhitzen abgetötet. Verzehrt werden ohne weitere listerienabtötende Behandlung z. Für mindestens zwei Minuten muss die Temperatur im Kern des Lebensmittels mindestens 70 Grad Celsius betragen. Nicht jeder der Keime aufnimmt muss erkranken.
Mit einfachen Lebensmittelhygiene-Maßnahmen können Sie zuverlässig Salmonellen abtöten. Fleisch auch genügend erhitzt werden Auch wenn die Herstellung und Zubereitung von Lebensmitteln einwandfrei ist ist eine nachträgliche Verunreinigung möglich. Risikopersonen sollten keine Lebensmittel tierischen Ursprungs roh verzehren wie etwa Mett. Zwischen den beiden Erhitzungsvorgängen sollte das Einweckgut am besten bei Raumtemperatur gelagert werden. Damit können Sie sicherstellen dass eventuell vorhandene Listerien abgetötet werden. Listerien vermehren sich bei Temperaturen zwischen -04 und 45C. Durch Kochen Braten und Pasteurisieren werden Listerien abgetötet.

Post a Comment for "Listerien Abtöten Durch Erhitzen"